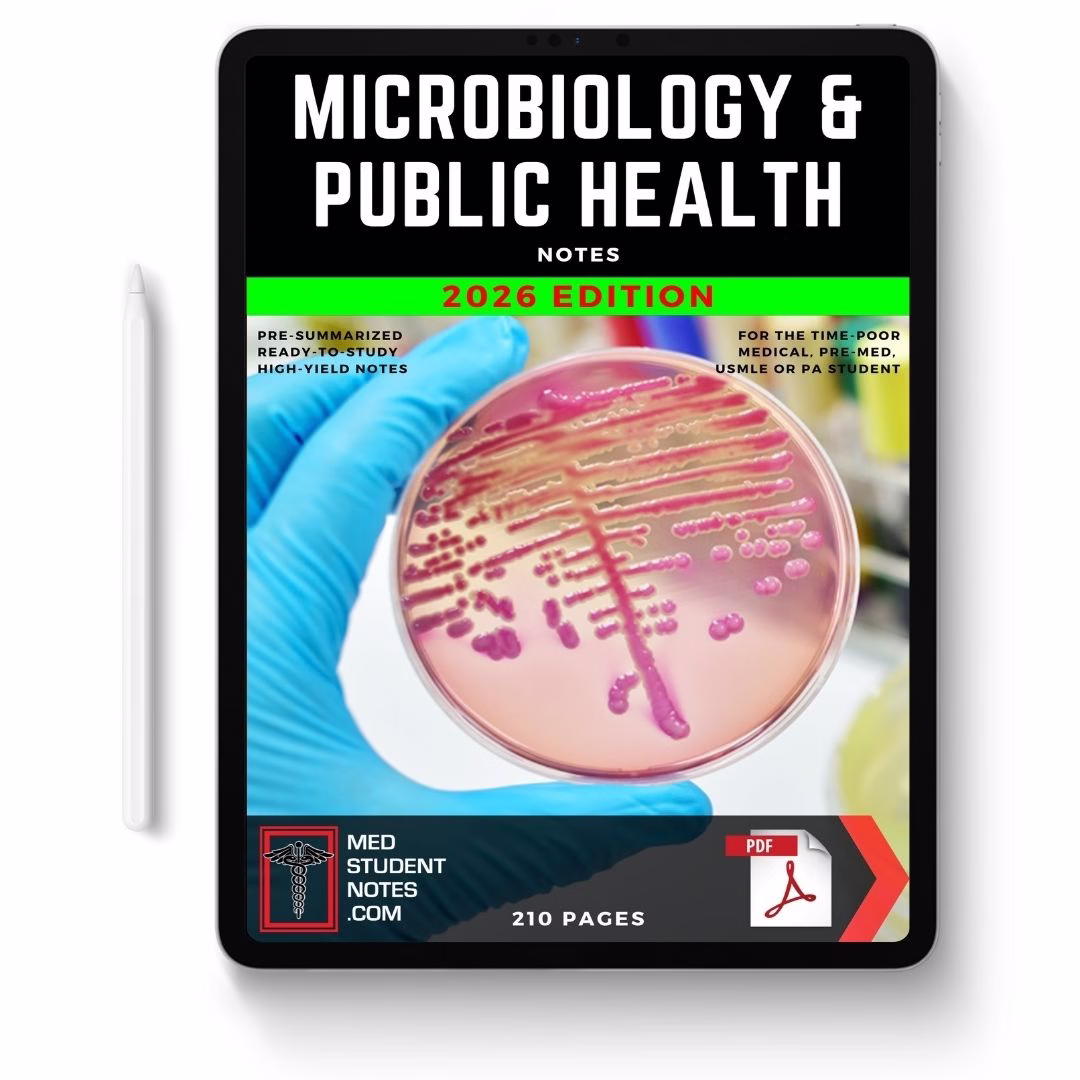
Microbiology & Public Health

Med Student Notes: The Complete Offline Bundle
Study smarter — not harder.
The MedStudentNotes Offline Bundle gives you instant offline access to over 700 high-yield medical topics spanning 20 core clinical subjects, all carefully organized and illustrated for rapid revision.
What’s Inside
A complete library covering:
Anatomy, Physiology, and Pathology of every system — plus Clinical Skills, Pharmacology, Emergency Medicine, Mental Health, and more.
Explore all 20 subjects:
Cardiovascular • Respiratory • Gastrointestinal • Nervous System • Musculoskeletal • Urinary & Renal • Endocrine • Blood & Haematology • Immune & Rheumatology • Skin & Dermatology • Reproductive Health • Obstetrics • Cell Biology & Biochemistry • Genetics & Cancer • Pharmacology & Toxicology • Emergency Medicine • Head & Neck • Clinical Skills • Microbiology & Public Health • Psychiatry & Mental Health
The Offline Bundle Includes
-
Full 20-Subject Library — all high-yield notes in one place
-
2300+ full-colour diagrams and clinical illustrations
-
Clickable internal links & smart navigation for seamless reading
-
Both PDF & ePUB formats — optimized for desktop, tablet, or mobile
-
Lifetime yearly updates included
-
Instant download access after checkout
-
Fully printable and yours to keep forever
Why Students Love It
-
Built by doctors, for medical students
-
Condenses complex topics into fast, exam-ready summaries
-
Works perfectly with your free online account — or offline when you need it most
One-Time Purchase — Only $29
Own the complete MedStudentNotes Offline Bundle today.
Download instantly, study anywhere, and keep it for life.